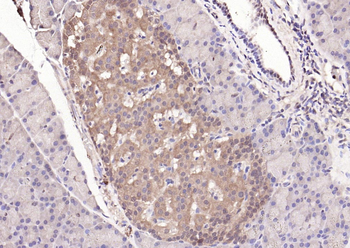
STAT3 Mouse Monoclonal Antibody

You have no items in your shopping cart.
- ACE2 Recombinant Rabbit Monoclonal Antibody [orb704176]Featured

ICC, IF, IHC-Fr, IHC-P, WB
Human, Mouse, Rat
Mouse, Rat
Rabbit
Recombinant
Unconjugated
50 μl, 100 μl, 25 μl - STAT3 Mouse Monoclonal Antibody [orb500764]Featured

IF, IHC-Fr, IHC-P, WB
Human, Mouse, Rat
Bovine
Mouse
Monoclonal
Unconjugated
200 μg, 200 μl, 50 μl, 100 μl - HMGB1 Rabbit Polyclonal Antibody [orb500823]Featured

FC, ICC, IF, IHC-Fr, IHC-P
Human, Mouse, Rat
Bovine, Canine, Equine, Porcine
Rabbit
Polyclonal
Unconjugated
50 μl, 100 μl, 200 μl - STAT1 Rabbit Polyclonal Antibody [orb158504]Featured

FC, ICC, IF, IHC-Fr, IHC-P, WB
Human, Mouse, Rat
Bovine, Canine, Equine, Porcine, Sheep
Rabbit
Polyclonal
Unconjugated
50 μl, 100 μl, 200 μl - JAK2 Rabbit Polyclonal Antibody [orb10948]Featured

FC, IF, IHC-Fr, IHC-P, WB
Human, Mouse, Rat
Bovine, Canine, Gallus, Porcine
Rabbit
Polyclonal
Unconjugated
50 μl, 100 μl, 200 μl - IRF3 Recombinant Rabbit Monoclonal Antibody [orb500087]
IF, IHC-Fr, IHC-P, WB
Human, Mouse
Rat
Rabbit
Recombinant
Unconjugated
25 μl, 50 μl, 100 μl - SARS-CoV-2 (COVID-19) Spike RBD Antibody [orb1239994]
ELISA, IF, IHC, WB
Virus
Rabbit
Polyclonal
Unconjugated
0.1 mg, 0.02 mg - ACE2 Antibody [orb1239144]Featured

ELISA, IF, IHC-P, WB
Human, Mouse, Rat
Bovine
Rabbit
Polyclonal
Unconjugated
0.1 mg, 0.02 mg - ACE2 Antibody [orb1239148]Featured

ELISA, IF, IHC-P, WB
Human, Mouse, Rat
Bovine
Rabbit
Polyclonal
Unconjugated
0.1 mg, 0.02 mg - CD13 Recombinant Rabbit Monoclonal Antibody [orb1151960]Featured

FC, ICC, IF, IHC-Fr, IHC-P, WB
Human, Mouse, Rat
Mouse, Rat
Rabbit
Recombinant
Unconjugated
25 μl, 100 μl, 50 μl